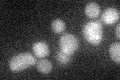
YHR048W
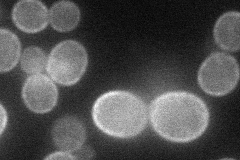
YHR048W

View description
Presumed antiporter of the DHA1 family of multidrug resistance transporters; contains 12 predicted transmembrane spans; expression of gene is up-regulated in cells exhibiting reduced susceptibility to azoles
Localization:
Intensity:
Fold change:
Significance:
-
C’ GFP library in SD
below threshold16.86 -
N' NOP1pr-GFP in SD
cell periphery37.1581 -
N' TEF2pr-mCherry in SD

cell periphery,vacuole56.4288 -
N' NATIVEpr-GFP in SD

below threshold18.7064 -
N' TEF2pr-VC and Cyto-VN in SD

cell periphery32.4664 -
C’ GFP library in SD+DTT

cytosol13.290.78No -
C’ GFP library in SD+H2O2

cytosol16.130.95No -
C’ GFP library in Starvation Media

cytosolN/AN/AYes -
C’ GFP library on the background of Pup2-DaMP

N/A -
C’ GFP library on the background of CCT mutant

N/A0N/AYes
